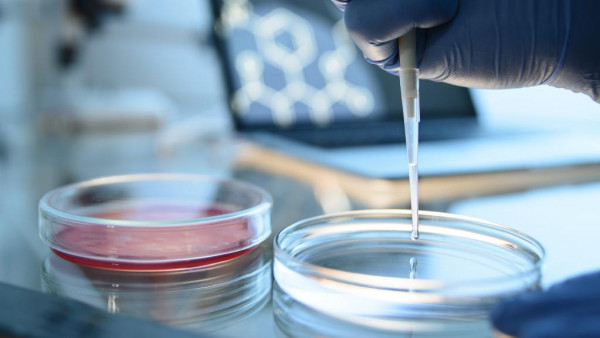

【今日澳洲8月14日讯】墨尔本华裔科学家叶克宇(Kiryu Yap,音译)领导的团队,正在用人体细胞来培育迷你肝脏组织,用于给病人移植,这在全球范围内还属首例。
(图片来源:《先驱太阳报》)
据《先驱太阳报》报道,墨尔本的St Vincent’s协会的The O’Brien研究所,以及St Vincent’s医院合作的一个项目中,使用癌症患者捐赠的细胞,已经培育出了几毫米长的肝组织。该项目由叶克宇(Kiryu Yap,音译)博士和Geraldine Mitchell医生主导,除了使用了人体细胞外,还使用了人源性肝凝胶和可生物降解的支架,用来组合创建迷你肝脏。

(图片来源:《先驱太阳报》)
叶博士称:“第一步是创造少量的肝脏组织,用于肝病患者身上,取代肝脏的一到两个功能。我们的长期目标是造出整个肝脏。”

(图片来源:《先驱太阳报》)
据悉澳洲每年有超过7000人死于慢性肝病,且预计随着肥胖率、2型糖尿病、病毒性肝炎以及酒精滥用的增加,这一人数还将上升。